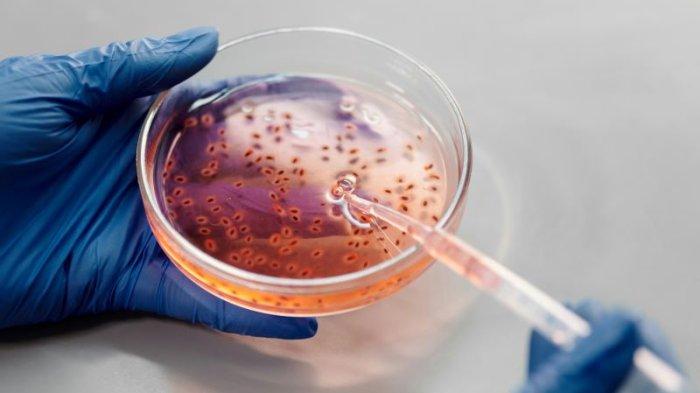

Kesehatan
Bakteri Pemakan Daging Tengah Mewabah di Jepang, Epidemiolog Beberkan Tips Agar Tak Tertular
Cara bakteri tersebut menghancurkan jaringan otot dan lemak di bawah kulit adalah dengan melepas toksin atau racun.
TRIBUNMANADO.CO.ID - Enam bulan pertama di tahun 2024 sudah lebih dari 1.000 laporan terkait wabah bakteri pemakan daging di Jepang.
Bakteri tersebut bernama Necrotizing Fasciitis.
Disebut pemakan daging karena jaringan ini menginfeksi jaringan lunak.
Hal itu menyebabkan kerusakan jaringan secara cepat dan luas.
Cara bakteri tersebut menghancurkan jaringan otot dan lemak di bawah kulit adalah dengan melepas toksin atau racun.
Kerusakan jaringan pada tubuh inilah yang menunjukkan seolah-olah bakteri sedang 'memakan daging'.
Terkait hal ini, Epidemiolog dan ahli kesehatan global Dicky Budiman bagikan cara bagaimana mencegah terjadinya penularan.
Sebelumnya Dicky menjelaskan bagaimana cara bakteri Necrotizing fasciitis menginfeksi manusia.
"Penularan terjadi melalui luka yang terbuka. Bakteri masuk lewat luka kecil atau luka bakar," ungkap Dicky pada Tribunnews, Senin (24/6/2024).
Oleh karena itu, pencegahan awal adalah saat mengalami luka harus segera dibersihkan.
Baca juga: Lirik Lagu Sigar - Denny Caknan
Baca juga: Lirik Lagu Heartache - One Ok Rock
Kedua, tutup luka sekecil apapun untuk mencegah masuknya bakteri.
Ketiga, hindari kontak dengan air yang berpotensi terkontaminasi bakteri atau patogen lain.
Keempat, segera cari perawatan medis kalau mengalami luka serius.
Selain itu Dicky mengimbau masyarakat untuk menerapkan perilaku hidup bersih dan sehat.
Tidak sampai di situ, masyarakat disarankan untuk melengkapi vaksin yang dianjurkan.

| Tips Jaga Kesehatan bagi Pekerja Kantoran yang Sering Duduk di Depan Komputer |

|
|---|
| 5 Tips Membuat Telur Rebus: Jangan Masak Terlalu Lama, Rendam Air Dingin |

|
|---|
| Daftar Khasiat Air Kelapa Muda Bagi Tubuh, Tetap Perlu Dibatasi |

|
|---|
| Akhirnya Terungkap Tujuan Presiden Prabowo Akan Buka 148 Prodi di 57 Fakultas Kedokteran |

|
|---|
| Daftar Cara Menurunkan Hipertensi, Mudah dan Alami |

|
|---|

![[FULL] Gibran Digugat Rp 125 T, Pakar: Ijazah Tak Harus dari Indonesia, Asal Sudah Diakui Setara SMA](https://img.youtube.com/vi/dYD1ATJ0-J8/mqdefault.jpg)





Isi komentar sepenuhnya adalah tanggung jawab pengguna dan diatur dalam UU ITE.